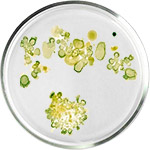
アルジースキンケア

成分で選ぶ
効果のあるナチュラルスキンケアをお探しなら、やっぱり大事なのは「成分」です。赤みやロザセアの悪化、面倒な吹き出物、あるいは年齢サインの初期段階など、どんなお悩みでも、効果的な天然成分や有効成分がたっぷり入った製品を選ぶことが、肌改善のカギになります。
FeelBeでは、プロフェッショナルも認める、肌の健康と美しさをサポートする天然成分を使ったコスメを取り扱っています。ビタミンCの明るくなる効果、ヒアルロン酸のしっかり潤う保湿力、アロエベラのやさしい鎮静効果など、成分で選ぶショッピング体験だからこそ、あなたの肌が本当に求めているものが迷わず見つかります。
ペプチドでコラーゲンを増やしたい?緑茶の抗酸化成分で肌を守りたい?それともセラミドで肌のバリア機能を修復したい?FeelBeなら、肌タイプやお悩み、好きな成分から簡単に商品を探せます。
肌のプロがすすめて、実際に多くの方に愛されている厳選スキンケア製品のラインナップをぜひご覧ください。あなたには、使って気持ちよくて、きちんと効果が実感できるスキンケアがふさわしいのです。